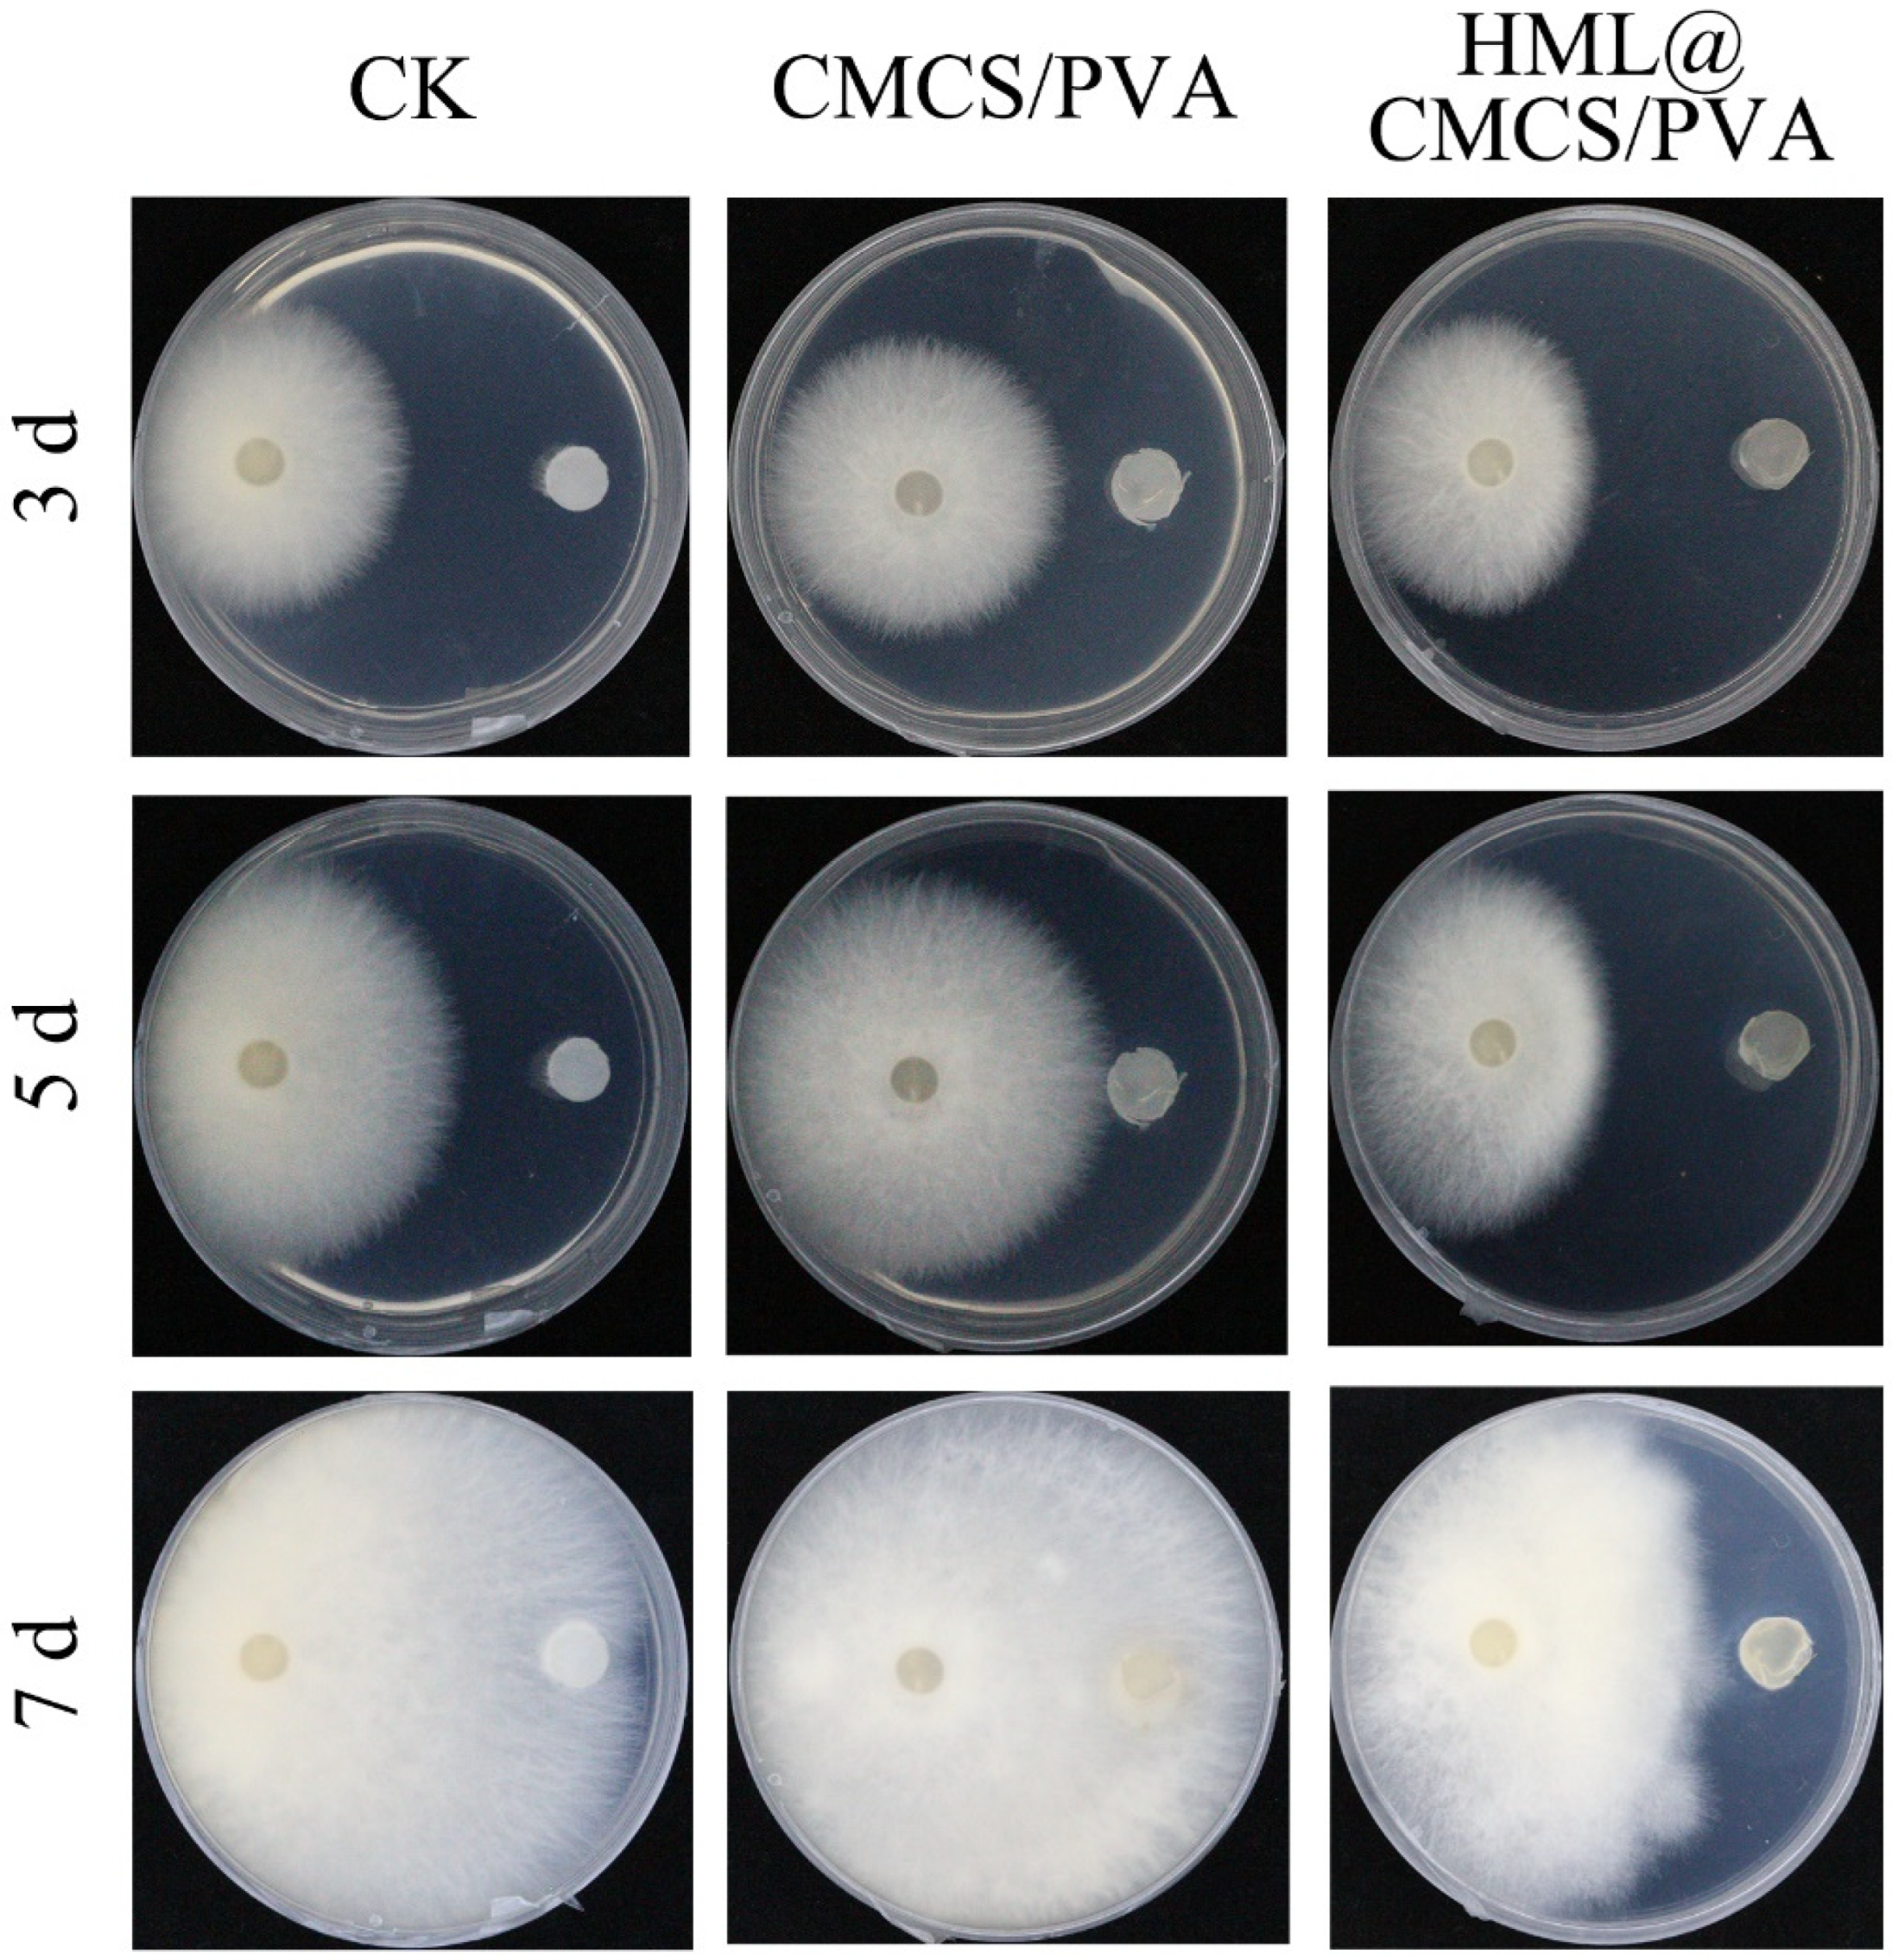
Agronomy 13 02205 g006

Biodegradable Carboxymethyl Chitosan/Polyvinyl Alcohol Hymexazol-Loaded Mulch Film for Soybean Root Rot Control
Abstract
:1. Introduction
2. Materials and Method
2.1. Materials
2.2. Preparation of Films
2.3. Characterization
2.3.1. SEM
2.3.2. Three-Dimensional Measurements
2.3.3. AFM
2.3.4. Mechanical Properties
2.3.5. Water Barrier Properties: WC, WS, WVP
2.3.6. Optional Properties: Transmittance and Transparency Properties and Color
2.3.7. XRD
2.3.8. FT-IR
2.4. In Vitro Antifungal Properties
2.5. Biosafety of Films to Earthworms
2.6. Soil Degradation Experiments
2.7. Statistical Analysis
3. Result and Discussion
3.1. Morphologies of Films
3.2. Mechanical Properties of Films
3.3. Water Barrier Properties of Films
3.4. Optical Properties of Films
3.5. FT-IR
3.6. XRD
3.7. In Vitro Antifungal Properties
3.8. Soil Degradation Experiments
3.9. Biosafety of Films to Earthworms
4. Conclusions
Author Contributions
Funding
Data Availability Statement
Acknowledgments
Conflicts of Interest
References
- Chang, X.; Wei, D.; Zeng, Y.; Zhao, X.; Hu, Y.; Wu, X.; Song, C.; Gong, G.; Chen, H.; Yang, C.; et al. Maize-soybean relay strip intercropping reshapes the rhizosphere bacterial community and recruits beneficial bacteria to suppress Fusarium root rot of soybean. Front. Microbiol. 2022, 13, 1009689. [Google Scholar] [CrossRef] [PubMed]
- Naeem, M.; Munir, M.; Li, H.; Raza, M.A.; Song, C.; Wu, X.; Irshad, G.; Khalid, M.H.B.; Yang, W.; Chang, X. Transcriptional Responses of Fusarium graminearum Interacted with Soybean to Cause Root Rot. J. Fungi 2021, 7, 422. [Google Scholar] [CrossRef] [PubMed]
- Barros, G.G.; Zanon, M.S.A.; Chiotta, M.L.; Reynoso, M.M.; Scandiani, M.M.; Chulze, S.N. Pathogenicity of phylogenetic species in the Fusarium graminearum complex on soybean seedlings in Argentina. Eur. J. Plant Pathol. 2013, 138, 215–222. [Google Scholar] [CrossRef]
- Xu, H.; Yan, L.; Zhang, M.; Chang, X.; Zhu, D.; Wei, D.; Naeem, M.; Song, C.; Wu, X.; Liu, T.; et al. Changes in the Density and Composition of Rhizosphere Pathogenic Fusarium and Beneficial Trichoderma Contributing to Reduced Root Rot of Intercropped Soybean. Pathogens 2022, 11, 478. [Google Scholar] [CrossRef] [PubMed]
- Cruz, D.R.; Leandro, L.F.S.; Mayfield, D.A.; Meng, Y.; Munkvold, G.P. Effects of Soil Conditions on Root Rot of Soybean Caused by Fusarium graminearum. Phytopathology 2020, 110, 1693–1703. [Google Scholar] [CrossRef] [PubMed]
- Zhang, W.; Li, S.; Shen, Y.; Yue, S. Film mulching affects root growth and function in dryland maize-soybean intercropping. Field Crops Res. 2021, 271, 108240. [Google Scholar] [CrossRef]
- Zhang, X.-L.; Zhao, Y.-Y.; Zhang, X.-T.; Shi, X.-P.; Shi, X.-Y.; Li, F.-M. Re-used mulching of plastic film is more profitable and environmentally friendly than new mulching. Soil Tillage Res. 2022, 216, 105256. [Google Scholar] [CrossRef]
- Helmberger, M.S.; Tiemann, L.K.; Grieshop, M.J.; Morriën, E. Towards an ecology of soil microplastics. Funct. Ecol. 2019, 34, 550–560. [Google Scholar] [CrossRef]
- Kedzierski, M.; Cirederf-Boulant, D.; Palazot, M.; Yvin, M.; Bruzaud, S. Continents of plastics: An estimate of the stock of microplastics in agricultural soils. Sci. Total Environ. 2023, 880, 163294. [Google Scholar] [CrossRef]
- Panda, P.K.; Sadeghi, K.; Seo, J. Recent advances in poly (vinyl alcohol)/natural polymer based films for food packaging applications: A review. Food Packag. Shelf Life 2022, 33, 100904. [Google Scholar] [CrossRef]
- El Hadrami, A.; Adam, L.R.; El Hadrami, I.; Daayf, F. Chitosan in plant protection. Mar. Drugs 2010, 8, 968–987. [Google Scholar] [CrossRef]
- Razmjoo, F.; Sadeghi, E.; Rouhi, M.; Mohammadi, R.; Noroozi, R.; Safajoo, S. Polyvinyl alcohol—Zedo gum edible film: Physical, mechanical and thermal properties. J. Appl. Polym. Sci. 2020, 138, 49875. [Google Scholar] [CrossRef]
- Xie, B.; Zhang, X.; Luo, X.; Wang, Y.; Li, Y.; Li, B.; Liu, S. Edible coating based on beeswax-in-water Pickering emulsion stabilized by cellulose nanofibrils and carboxymethyl chitosan. Food Chem. 2020, 331, 127108. [Google Scholar] [CrossRef]
- Kritchenkov, A.S.; Egorov, A.R.; Volkova, O.V.; Artemjev, A.A.; Kurliuk, A.V.; Anh Le, T.; Hieu Truong, H.; Le-Nhat-Thuy, G.; Van Tran Thi, T.; Van Tuyen, N.; et al. Novel biopolymer-based nanocomposite food coatings that exhibit active and smart properties due to a single type of nanoparticles. Food Chem. 2021, 343, 128676. [Google Scholar] [CrossRef]
- Kritchenkov, A.S.; Egorov, A.R.; Volkova, O.V.; Zabodalova, L.A.; Suchkova, E.P.; Yagafarov, N.Z.; Kurasova, M.N.; Dysin, A.P.; Kurliuk, A.V.; Shakola, T.V.; et al. Active antibacterial food coatings based on blends of succinyl chitosan and triazole betaine chitosan derivatives. Food Packag. Shelf Life 2020, 25, 100534. [Google Scholar] [CrossRef]
- Zimet, P.; Mombru, A.W.; Mombru, D.; Castro, A.; Villanueva, J.P.; Pardo, H.; Rufo, C. Physico-chemical and antilisterial properties of nisin-incorporated chitosan/carboxymethyl chitosan films. Carbohydr. Polym. 2019, 219, 334–343. [Google Scholar] [CrossRef]
- de Lacerda Bukzem, A.; Dos Santos, D.M.; Leite, I.S.; Inada, N.M.; Campana-Filho, S.P. Tuning the properties of carboxymethylchitosan-based porous membranes for potential application as wound dressing. Int. J. Biol. Macromol. 2021, 166, 459–470. [Google Scholar] [CrossRef]
- Wang, Y.; Cen, C.; Chen, J.; Fu, L. MgO/carboxymethyl chitosan nanocomposite improves thermal stability, waterproof and antibacterial performance for food packaging. Carbohydr. Polym. 2020, 236, 116078. [Google Scholar] [CrossRef]
- Mitrea, L.; Calinoiu, L.F.; Martau, G.A.; Szabo, K.; Teleky, B.E.; Muresan, V.; Rusu, A.V.; Socol, C.T.; Vodnar, D.C. Poly(vinyl alcohol)-Based Biofilms Plasticized with Polyols and Colored with Pigments Extracted from Tomato By-Products. Polymers 2020, 12, 532. [Google Scholar] [CrossRef]
- Panda, P.K.; Park, K.; Seo, J. Development of poly (vinyl alcohol)/regenerated chitosan blend film with superior barrier, antioxidant, and antibacterial properties. Prog. Org. Coat. 2023, 183, 107749. [Google Scholar] [CrossRef]
- Kanatt, S.R.; Rao, M.S.; Chawla, S.P.; Sharma, A. Active chitosan–polyvinyl alcohol films with natural extracts. Food Hydrocoll. 2012, 29, 290–297. [Google Scholar] [CrossRef]
- Yang, W.; Owczarek, J.S.; Fortunati, E.; Kozanecki, M.; Mazzaglia, A.; Balestra, G.M.; Kenny, J.M.; Torre, L.; Puglia, D. Antioxidant and antibacterial lignin nanoparticles in polyvinyl alcohol/chitosan films for active packaging. Ind. Crops Prod. 2016, 94, 800–811. [Google Scholar] [CrossRef]
- Liang, W.; Zhao, Y.; Xiao, D.; Cheng, J.; Zhao, J. A biodegradable water-triggered chitosan/hydroxypropyl methylcellulose pesticide mulch film for sustained control of Phytophthora sojae in soybean (Glycine max L. Merr.). J. Clean. Prod. 2020, 245, 118943. [Google Scholar] [CrossRef]
- Bonilla, J.; Fortunati, E.; Vargas, M.; Chiralt, A.; Kenny, J.M. Effects of chitosan on the physicochemical and antimicrobial properties of PLA films. J. Food Eng. 2013, 119, 236–243. [Google Scholar] [CrossRef]
- Ekambaram, K.; Doraisamy, M. Fouling resistant PVDF/Carboxymethyl chitosan composite nanofiltration membranes for humic acid removal. Carbohydr. Polym. 2017, 173, 431–440. [Google Scholar] [CrossRef]
- Pereira, V.A.; de Arruda, I.N.Q.; Stefani, R. Active chitosan/PVA films with anthocyanins from Brassica oleraceae (Red Cabbage) as Time–Temperature Indicators for application in intelligent food packaging. Food Hydrocoll. 2015, 43, 180–188. [Google Scholar] [CrossRef]
- Atarés, L.; Bonilla, J.; Chiralt, A. Characterization of sodium caseinate-based edible films incorporated with cinnamon or ginger essential oils. J. Food Eng. 2010, 100, 678–687. [Google Scholar] [CrossRef]
- Ding, W.; Li, Z.; Qi, R.; Jones, D.L.; Liu, Q.; Liu, Q.; Yan, C. Effect thresholds for the earthworm Eisenia fetida: Toxicity comparison between conventional and biodegradable microplastics. Sci. Total Environ. 2021, 781, 146884. [Google Scholar] [CrossRef]
- La Mantia, F.P.; Ascione, L.; Mistretta, M.C.; Rapisarda, M.; Rizzarelli, P. Comparative Investigation on the Soil Burial Degradation Behaviour of Polymer Films for Agriculture before and after Photo-Oxidation. Polymers 2020, 12, 753. [Google Scholar] [CrossRef]
- Zhang, Y.; Zhao, W.; Lin, Z.; Tang, Z.; Lin, B. Carboxymethyl chitosan/sodium alginate hydrogel films with good biocompatibility and reproducibility by in situ ultra-fast crosslinking for efficient preservation of strawberry. Carbohydr. Polym. 2023, 316, 121073. [Google Scholar] [CrossRef]
- Tao, F.; Cheng, Y.; Tao, H.; Jin, L.; Wan, Z.; Dai, F.; Xiang, W.; Deng, H. Carboxymethyl chitosan/sodium alginate-based micron-fibers fabricated by emulsion electrospinning for periosteal tissue engineering. Mater. Des. 2020, 194, 108849. [Google Scholar] [CrossRef]
- Yang, H.; Guo, X.; Chen, R.; Liu, Q.; Liu, J.; Yu, J.; Lin, C.; Wang, J.; Zhang, M. Enhanced anti-biofouling ability of polyurethane anti-cavitation coating with ZIF-8: A comparative study of various sizes of ZIF-8 on coating. Eur. Polym. J. 2021, 144, 110212. [Google Scholar] [CrossRef]
- Samide, A.; Iacobescu, G.E.; Tutunaru, B.; Iordache, S. Silver nanoparticles/polyvinyl alcohol film: Studies of thermal characterization, AFM and corrosion protection by electrodeposition on 304L stainless steel. J. Therm. Anal. Calorim. 2021, 147, 1041–1051. [Google Scholar] [CrossRef]
- Yin, M.; Chen, X.; Li, R.; Huang, D.; Fan, X.; Ren, X.; Huang, T.-S. Preparation and characterization of antimicrobial PVA hybrid films withN-halamine modified chitosan nanospheres. J. Appl. Polym. Sci. 2016, 133, 44204. [Google Scholar] [CrossRef]
- Yoon, S.D.; Kim, Y.M.; Kim, B.I.; Je, J.Y. Preparation and antibacterial activities of chitosan-gallic acid/polyvinyl alcohol blend film by LED-UV irradiation. J. Photochem. Photobiol. B 2017, 176, 145–149. [Google Scholar] [CrossRef]
- Yin, M.; Lin, X.; Ren, T.; Li, Z.; Ren, X.; Huang, T.S. Cytocompatible quaternized carboxymethyl chitosan/poly(vinyl alcohol) blend film loaded copper for antibacterial application. Int. J. Biol. Macromol. 2018, 120, 992–998. [Google Scholar] [CrossRef]
- Sun, W.; Liu, X.; Li, X.; Wang, S.; Li, Q.; Sun, Z. A method for the treatment of black tea waste: Converting it into liquid mulching film and solid mulching film. J. Appl. Polym. Sci. 2022, 140, e53481. [Google Scholar] [CrossRef]
- Wang, L.-C.; Chen, X.-G.; Yu, L.-J.; Li, P.-W. Controlled drug release through carboxymethyl-chitosan/poly(vinyl alcohol) blend films. Polym. Eng. Sci. 2007, 47, 1373–1379. [Google Scholar] [CrossRef]
- Meera, K.; Ramesan, M.T. Performance of Boehmite Nanoparticles Reinforced Carboxymethyl Chitosan/Polyvinyl Alcohol Blend Nanocomposites Tailored Through Green Synthesis. J. Polym. Environ. 2022, 31, 447–460. [Google Scholar] [CrossRef]
- Yang, N.; Sun, Z.-X.; Feng, L.-S.; Zheng, M.-Z.; Chi, D.-C.; Meng, W.-Z.; Hou, Z.-Y.; Bai, W.; Li, K.-Y. Plastic Film Mulching for Water-Efficient Agricultural Applications and Degradable Films Materials Development Research. Mater. Manuf. Process. 2014, 30, 143–154. [Google Scholar] [CrossRef]
- Adhikari, R.; Bristow, K.L.; Casey, P.S.; Freischmidt, G.; Hornbuckle, J.W.; Adhikari, B. Preformed and sprayable polymeric mulch film to improve agricultural water use efficiency. Agric. Water Manag. 2016, 169, 1–13. [Google Scholar] [CrossRef]
- Zhang, X.; Gao, D.; Luo, W.; Xiao, N.; Xiao, G.; Li, Z.; Liu, C. Hemicelluloses-based sprayable and biodegradable pesticide mulch films for Chinese cabbage growth. Int. J. Biol. Macromol. 2023, 225, 1350–1360. [Google Scholar] [CrossRef] [PubMed]
- Xie, Z.; Xiong, Q.; Fang, Y.; Zhang, Q.; Liang, W.; Cheng, J.; Shang, W.; Zhao, W.; Zhao, J. Novel Biodegradable Composite Mulch Film Embedded with Temperature-Responsive Pesticide Microcapsules for Durable Control of Phytophthora Root Rot on Soybean. ACS Sustain. Chem. Eng. 2023, 11, 9868–9879. [Google Scholar] [CrossRef]
- Briassoulis, D.; Giannoulis, A. Evaluation of the functionality of bio-based plastic mulching films. Polym. Test. 2018, 67, 99–109. [Google Scholar] [CrossRef]
- Suriyatem, R.; Auras, R.A.; Rachtanapun, P. Improvement of mechanical properties and thermal stability of biodegradable rice starch–based films blended with carboxymethyl chitosan. Ind. Crops Prod. 2018, 122, 37–48. [Google Scholar] [CrossRef]
- Wu, J.; Zhong, F.; Li, Y.; Shoemaker, C.F.; Xia, W. Preparation and characterization of pullulan–chitosan and pullulan–carboxymethyl chitosan blended films. Food Hydrocoll. 2013, 30, 82–91. [Google Scholar] [CrossRef]
- Lan, W.; He, L.; Liu, Y. Preparation and Properties of Sodium Carboxymethyl Cellulose/Sodium Alginate/Chitosan Composite Film. Coatings 2018, 8, 291. [Google Scholar] [CrossRef]
- Zhuang, T.T.; Liu, Y.; Li, Y.; Zhao, Y.; Wu, L.; Jiang, J.; Yu, S.H. Integration of Semiconducting Sulfides for Full-Spectrum Solar Energy Absorption and Efficient Charge Separation. Angew. Chem. Int. Ed. Engl. 2016, 55, 6396–6400. [Google Scholar] [CrossRef]
- Cui, J.; Li, Y.; Liu, L.; Chen, L.; Xu, J.; Ma, J.; Fang, G.; Zhu, E.; Wu, H.; Zhao, L.; et al. Near-Infrared Plasmonic-Enhanced Solar Energy Harvest for Highly Efficient Photocatalytic Reactions. Nano Lett. 2015, 15, 6295–6301. [Google Scholar] [CrossRef]
- Zhao, J.; Jiang, H.; Huang, Q.; Xu, J.; Duan, M.; Yu, S.; Zhi, Z.; Pang, J.; Wu, C. Carboxymethyl chitosan incorporated with gliadin/phlorotannin nanoparticles enables the formation of new active packaging films. Int. J. Biol. Macromol. 2022, 203, 40–48. [Google Scholar] [CrossRef]
- Wang, L.; Lei, L.; Wan, K.; Fu, Y.; Hu, H. Physicochemical Properties and Biological Activity of Active Films Based on Corn Peptide Incorporated Carboxymethyl Chitosan. Coatings 2021, 11, 604. [Google Scholar] [CrossRef]
- Hong, J.; Chen, R.; Zeng, X.A.; Han, Z. Effect of pulsed electric fields assisted acetylation on morphological, structural and functional characteristics of potato starch. Food Chem. 2016, 192, 15–24. [Google Scholar] [CrossRef] [PubMed]
- Liu, L.; Liu, Y.; Liu, Y.; Wang, Q. Efficient flame retardant polyvinyl alcohol membrane through surface graft method. RSC Adv. 2016, 6, 35051–35057. [Google Scholar] [CrossRef]
- Zhao, M.; Zhou, H.; Chen, L.; Hao, L.; Chen, H.; Zhou, X. Carboxymethyl chitosan grafted trisiloxane surfactant nanoparticles with pH sensitivity for sustained release of pesticide. Carbohydr. Polym. 2020, 243, 116433. [Google Scholar] [CrossRef] [PubMed]
- Rao, K.M.; Sudhakar, K.; Suneetha, M.; Won, S.Y.; Han, S.S. Fungal-derived carboxymethyl chitosan blended with polyvinyl alcohol as membranes for wound dressings. Int. J. Biol. Macromol. 2021, 190, 792–800. [Google Scholar] [CrossRef] [PubMed]
- Choo, K.; Ching, Y.C.; Chuah, C.H.; Julai, S.; Liou, N.S. Preparation and Characterization of Polyvinyl Alcohol-Chitosan Composite Films Reinforced with Cellulose Nanofiber. Materials 2016, 9, 644. [Google Scholar] [CrossRef]
- Liu, J.; Zhu, L.; Luo, S.; Bu, L.; Chen, X.; Yue, S.; Li, S. Response of nitrous oxide emission to soil mulching and nitrogen fertilization in semi-arid farmland. Agric. Ecosyst. Environ. 2014, 188, 20–28. [Google Scholar] [CrossRef]
- Pires, J.R.A.; Souza, V.G.L.; Fucinos, P.; Pastrana, L.; Fernando, A.L. Methodologies to Assess the Biodegradability of Bio-Based Polymers-Current Knowledge and Existing Gaps. Polymers 2022, 14, 1359. [Google Scholar] [CrossRef]
- Gao, X.; Xie, D.; Yang, C. Effects of a PLA/PBAT biodegradable film mulch as a replacement of polyethylene film and their residues on crop and soil environment. Agric. Water Manag. 2021, 255, 107053. [Google Scholar] [CrossRef]
- Zhang, L.; Sintim, H.Y.; Bary, A.I.; Hayes, D.G.; Wadsworth, L.C.; Anunciado, M.B.; Flury, M. Interaction of Lumbricus terrestris with macroscopic polyethylene and biodegradable plastic mulch. Sci. Total Environ. 2018, 635, 1600–1608. [Google Scholar] [CrossRef]
- Food SecurityCheng, Y.; Zhu, L.; Song, W.; Jiang, C.; Li, B.; Du, Z.; Wang, J.; Wang, J.; Li, D.; Zhang, K. Combined effects of mulch film-derived microplastics and atrazine on oxidative stress and gene expression in earthworm (Eisenia fetida). Sci. Total Environ. 2020, 746, 141280. [Google Scholar] [CrossRef]

| Film | Ra | Rz | Rq |
|---|---|---|---|
| HML@CMCS | 51.804 | 258.990 | 61.648 |
| HML@PVA | 2.779 | 31.476 | 3.779 |
| HML@CMCS/PVA | 13.765 | 89.177 | 17.17 |
| Film | WVP (g mm/h m2 kPa) | L* | a* | b* | ΔE |
|---|---|---|---|---|---|
| HML@CMCS | 0.4852 | 88.392 (0.092) c | −1.972 (0.010) c | 5.584 (0.226) a | 10.234 (0.242) b |
| HML@PVA | 0.8380 | 91.754 (0.062) a | −1.246 (0.015) a | −3.956 (0.042) c | 0.158 (0.045) c |
| HML@CMCS/PVA | 0.7716 | 89.903 (0.032) b | −1.363 (0.029) b | −0.157 (0.159) b | 18.783 (1.357) a |
Disclaimer/Publisher’s Note: The statements, opinions and data contained in all publications are solely those of the individual author(s) and contributor(s) and not of MDPI and/or the editor(s). MDPI and/or the editor(s) disclaim responsibility for any injury to people or property resulting from any ideas, methods, instructions or products referred to in the content. |
© 2023 by the authors. Licensee MDPI, Basel, Switzerland. This article is an open access article distributed under the terms and conditions of the Creative Commons Attribution (CC BY) license (https://creativecommons.org/licenses/by/4.0/).
Share and Cite
Lv, Z.; Meng, X.; Sun, S.; Jiang, T.; Zhang, S.; Feng, J. Biodegradable Carboxymethyl Chitosan/Polyvinyl Alcohol Hymexazol-Loaded Mulch Film for Soybean Root Rot Control. Agronomy 2023, 13, 2205. https://doi.org/10.3390/agronomy13092205
Lv Z, Meng X, Sun S, Jiang T, Zhang S, Feng J. Biodegradable Carboxymethyl Chitosan/Polyvinyl Alcohol Hymexazol-Loaded Mulch Film for Soybean Root Rot Control. Agronomy. 2023; 13(9):2205. https://doi.org/10.3390/agronomy13092205
Chicago/Turabian StyleLv, Ze, Xiaohan Meng, Shaoyang Sun, Tianzhen Jiang, Shengfu Zhang, and Jianguo Feng. 2023. "Biodegradable Carboxymethyl Chitosan/Polyvinyl Alcohol Hymexazol-Loaded Mulch Film for Soybean Root Rot Control" Agronomy 13, no. 9: 2205. https://doi.org/10.3390/agronomy13092205
APA StyleLv, Z., Meng, X., Sun, S., Jiang, T., Zhang, S., & Feng, J. (2023). Biodegradable Carboxymethyl Chitosan/Polyvinyl Alcohol Hymexazol-Loaded Mulch Film for Soybean Root Rot Control. Agronomy, 13(9), 2205. https://doi.org/10.3390/agronomy13092205





